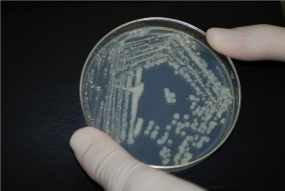
disc sample in petri dish

False-Positive Investigation Toolkit: A Resource for Mycobacteriology Laboratories
False-positive Mycobacterium tuberculosis complex (MTBC) results can be difficult to identify, investigate, and resolve. False-positive results often have serious implications for patient isolation, patient therapy, contact investigations, and unnecessary laboratory testing. This project, the False-Positive Investigation Toolkit, was developed to provide mycobacteriology staff with updated resources to recognize potential false-positive results and to assist staff in false-positive investigations. In addition, TB Control programs and healthcare providers may also find this information beneficial when investigating potential false-positive laboratory results.
The toolkit includes job-aids, posters, and templates that can be modified for local use.
An accompanying online interactive case study training module, Mycobacteriology False-Positive Case Studies, can be found on the Association of Public Health Laboratories website. The training module walks through different scenarios of a potential false-positive investigation.
For a summary of the toolkit, download the False Positive Investigation Toolkit Overview.
Access the resources here:
False-positive Mycobacterium tuberculosis complex (MTBC) results can be difficult to identify, investigate, and resolve. False-positive results often have serious implications for patient isolation, patient therapy, contact investigations, and unnecessary laboratory testing. Errors leading to false- positive results can be classified as pre-analytic, analytic, or post-analytic. In any mycobacteriology laboratory, cross-contamination, mislabeling errors, specimen mix-ups, and use of nonsterile reagents can cause the inadvertent transfer of bacilli from one specimen or culture to another specimen or culture.
In 1997, the Centers for Disease Control and Prevention (CDC) and the Association of State and Territorial Public Health Laboratory Directors [now known as Association of Public Health Laboratories (APHL)] developed a video and 28-page booklet titled “Recognition and Prevention of False-Positive Test Results in Mycobacteriology —A Laboratory Training Program.” The program was designed to help laboratorians recognize and prevent false-positive test results in mycobacteriology. Since 1997, the program has not been updated and similar publications have been limited in recent years.
This project, the False-Positive Investigation Toolkit, was developed to provide mycobacteriology staff with updated resources to recognize potential false-positive results and to assist staff in false- positive investigations.
The toolkit’s primary audience is mycobacteriology laboratory supervisors, technologists, and quality- assurance staff members. In addition, TB Control programs and healthcare providers may also find this information beneficial when investigating potential false-positive laboratory results.
Objectives for this false-positive investigation toolkit include:
- Define false-positive results for MTBC.
- Identify best practices to prevent false-positive results for MTBC.
- Recognize possible scenarios for identifying potential false-positive results.
- Describe the actions necessary to investigate potential false-positive results.
- Summarize how the TB laboratory and the TB Control Program should collaborate to investigate false-positive results.
- Describe the importance of developing both laboratory and TB Control Program guidance, policies, and educational materials to be referenced by staff when necessary.
- Identify follow-up actions if a determination of false-positive result is made.
The toolkit includes a document that can be reviewed and referred to and job aids, posters, and templates. The job aids and templates can be modified for local use and should not be sent to CDC for data collection. An accompanying online interactive case study training module can be accessed on the APHL website (www.aphl.org/TB). This training module provides an opportunity to walk through different scenarios of a potential false-positive investigation, using knowledge checks to guide the participant.
The Clinical and Laboratory Standards Institute (CLSI) Laboratory Detection and Identification of Mycobacteria, 2nd ed. M48 Mycobacteriology Laboratory Guidance (2018) has been referenced throughout this toolkit (1). Because of its broad use, this document should be consulted when further guidance is warranted. Additional references are cited as applicable.
The findings and conclusions in this report are those of the author(s) and do not necessarily represent the views of the Centers for Disease Control and Prevention.
Use of trade names and commercial sources is for identification only and does not imply endorsement by the U.S. Department of Health and Human Services.
Suggested Citation:
CDC. False-Positive Investigation Toolkit : A Resource for Mycobacteriology Laboratories. Atlanta, Ga: Department of Health and Human Services, CDC; December 2019. www.cy118119.com/tb/publications/ guidestoolkits/false_positive/False-Positive.htm
AFB: Acid-fast bacilli
AFB culture: Acid-fast bacilli culture. The inoculation of a clinical specimen into culture media such as Becton Dickinson Mycobacteria Growth Indicator Tube (BD MGIT broth) or onto Middlebrook 7H11 or Lowenstein-Jensen (LJ) media slant with incubation at 36±1°C for up to six (6) to eight (8) weeks and detection or observation of growth or no growth during this incubation period.
AFB smear: Acid-fast bacilli smear. The microscopic examination of a Kinyoun, Ziehl-Neelsen, or fluorochrome stain of a clinical specimen.
BacTec MGIT™: Mycobacteria Growth Indicator Tube, Becton Dickinson and Co. A commercial, nonradiometric, broth-based mycobacterial culture system.
BSC: Biological safety cabinet
CAP: College of American Pathologists
Contamination: Inadvertent addition of target analytes to samples during sample collection, transportation, and analysis process
Cross-contamination: Act of spreading foreign or undesired material from one surface to another.
Epidemiologic links: Term used to identify whether individuals have a known connection through case interviews or contact investigations.
False-Positive: Error in which a test result improperly indicates presence of a condition, such as a disease.
Genotype: Genetic constitution of an individual organism used to distinguish different strains of bacteria.
Isolate: Culture growth of microorganisms isolated for testing.
LIMS: Laboratory Information Management System
MTBC: Mycobacterium tuberculosis complex
Nonconforming event (NCE): an unapproved departure (nonconformance) from a documented requirement or procedure (e.g., regulation, statute, policy, procedure, customer requirement)
NTM: Nontuberculous mycobacteria
PHL: Public health laboratory
PPE: Personal Protective Equipment. Equipment worn to minimize exposure to hazards that cause serious workplace injuries and illnesses.
Quality control (QC): Processes and products used to ensure that testing procedures are performed accurately by achieving expected results.
Specimen processing log: Log that is used in the laboratory to record when and how a specimen was processed, tested, and resulted.
Sputum: Mucous secretion from the lungs, bronchi, and trachea that is expectorated through the mouth.
TAT: Turnaround time
TB: Tuberculosis
In any mycobacteriology laboratory, false-positive results can occur from the inadvertent transfer of bacilli from one specimen or culture to another specimen or culture through cross-contamination, mislabeling errors, specimen mix-ups, or the use of nonsterile reagents. False-positive Mycobacterium tuberculosis complex (MTBC) results can be caused by pre-analytic, analytic (laboratory practices), and post-analytic errors. Information from each of these three areas will be described on the following pages for readers to refer to and utilize during potential false-positive investigations.
A. Pre-Analytic Prevention Practices

Specimens submitted to a laboratory should be properly collected, labeled, stored, and transported. Each of these processes can affect specimen quality, accuracy of test results, and can result in false- positive results. It may be helpful for laboratories to create specimen collection and submission guidelines for submitters that includes information regarding acceptable specimen types, minimum volumes, collection techniques, labeling, storage, transport, and laboratory rejection criteria (2).
It is important to properly collect adequate specimens of acceptable quality for laboratory testing. Contamination can be introduced at the time of collection. For optimal sputum specimens, patients should be instructed on proper specimen collection techniques to ensure a quality specimen is collected. The material should be mucoid and not saliva or spit. Specimens should not be overtly bloody. The minimum volume of sputum collected should be 3mL (1). The specimen should be collected completely inside a sterile container and material should not be on the outside of the container. For guidance on other specimen types, please refer to Table 3 in CLSI M48, 2nd Edition (1).
Each specimen container, labeled prior to time of collection, should have the correct patient name and a unique identifying number (two patient identifiers) clearly written or printed on the specimen container. It is best practice for the submitter to match the patient specimen to the specimen test order requisition form. Patient name and identifiers on the collection container should match what is written or printed on the test order requisition form.
Specimen containers should be properly closed using the container threads and sealed using laboratory film or another suitable material before transport or shipping. Packaging and shipping for diagnostic mycobacteriology specimens should be in accordance with Department of Transportation (DOT) and the International Air Transport Association (IATA) packaging requirements for UN 3373 Biological Substance, Category B.
Proper storage and prompt transport of diagnostic specimens (e.g., sputum, other specimen types) from the collection site or submitter to the testing laboratory is extremely important for quality test results and efficient result reporting. Collection sites should refrigerate diagnostic specimens that cannot be transported immediately in order to reduce overgrowth of contaminating organisms. Specimens should be delivered to the laboratory as soon as possible (within 24 hours of collection being optimal) and specimens should not be batched for shipment if at all possible (3). Specimens collected at the end of the day or on a Friday, when transport may not be available, should be stored in the site’s refrigerator and then transported with a cold pack and delivered to the laboratory the following morning or after the weekend (4).
B. Labratory Prevention Practices – Analytic

Laboratories that perform mycobacteriology testing should ensure that appropriate practices and procedures are in place to avoid cross-contamination. Best practices are those methods, techniques, or processes that have been generally accepted through experience and research to be reliable and lead to an accurate result. These processes may reduce the likelihood of false-positive test results, or could simplify investigating, identifying, or resolving potential false- positive situations.
i. Specimen Processing
When processing specimens from patients that are documented as known acid-fast bacilli (AFB) positive, there is an increased opportunity for the carryover of organisms from positive to negative specimens. Production of aerosolized particles during processing of smear-positive specimens, use of MTBC as a positive control, or contamination of reagents are major causes of cross-contamination (5). The use of best practices should reduce the opportunity for transfer from positive to negative specimens. Laboratory policies and procedures should be designed to minimize the risk of potential cross-contamination:
- Use of separate biological safety cabinets (BSC) if possible:
When feasible, do not use the same BSC for processing initial diagnostic specimens and known positive patient specimens or isolates to prevent cross-contamination (6, 7). If only one BSC is available, ensure that diagnostic specimens are not handled at the same time as culture growth and that the BSC is decontaminated between processing batches. - Use individual aliquots of reagents for each specimen being processed:
Never use a common flask or beaker to dispense reagents (5, 8, 9, 10). Use individual or daily aliquots of processing reagents and buffers and discard any leftover reagents not used that day (4). - Avoid processing large batches of specimens:
Processing large numbers of specimens at one time increases the odds that aerosolization from a positive specimen with MTBC will contaminate adjacent specimens (2, 11). Process specimens in a batch size small enough to maintain the timing of the digestion- decontamination step. Additionally, only process the number of specimens than can be placed in a centrifuge at one time. - Process known AFB smear-positive clinical specimens either after or separately from other specimens:
AFB smear-positive specimens are more likely than smear-negative specimens to be a source of cross-contamination during batch processing (12). Separately processing specimens from patients previously known to be smear- or culture-positive can significantly reduce the rate of false-positive results in a laboratory (13). If processing separate batches is not feasible, the laboratory should consider placing these specimens at the end of the processing batch. - A negative control should be included with each batch of cultures that are inoculated to monitor for contamination (4):
The negative control may be 5 to 10 mL of sterile water, broth, or buffer placed at the end of the processing batch and should be processed in the same manner as patient specimens. A note of caution: a negative control can be negative yet cross-contamination within a batch may have still occurred. The negative control would likely pick up a large contamination issue but not necessarily an isolated issue. - Do not process patient specimens in the same batch as laboratory proficiency testing (PT) samples or quality control (QC) strains:
Batch processing highly smear- and culture-positive strains used for proficiency surveys with clinical specimens can result in cross-contamination (12). Process PT and QC strains in separate batches and preferably not in the same BSC used for patient specimens. - Use caution when using positive controls:
M. tuberculosis is a hardy organism that can survive in the laboratory and contaminate patient clinical specimens. Cross-contamination of patient specimens in a laboratory that used the avirulent control strain H37Ra in the same BSC on a different day than specimen processing has been documented (14, 15). Laboratories should be sure to follow decontamination practices after use of positive controls. - Handle specimen containers properly during processing:
- Leave a space between tubes in the rack.
- Keep specimen tubes tightly closed and clean the outside of each tube before vortexing or shaking.
- When adding reagents, open only one tube at a time.
- Pour reagents slowly down the side of the inside of the tube to avoid splashing and creating aerosols.
- Never touch the lip of the tube with the reagent ontainer.
- After mixing or vortexing, wait five minutes before opening tubes to allow aerosols to settle.
- Open tubes gently to avoid aerosol generation.
- Use a discard container that is splash proof when pouring off reagents.
- BSCs must be used properly (16):
- Do not impede or disturb the airflow during specimen processing.
- Place materials as far back inside the BSC as is comfortable, without blocking the rear grill.
- Place aerosol-generating equipment (e.g., vortex mixers, mini-centrifuges) towards the rear of the cabinet.
- Place discard pans to one side of the cabinet interior.
- Use absorbent pads soaked in disinfectant on the work surface to minimize splatter and aerosol generation in case of spillage.
- Decontaminate work surfaces before and after using the BSC.
ii. AFB Smear Microscopy

A patient sputum specimen with a positive AFB smear result with a subsequent culture that is negative for growth with no clinical evidence of pulmonary TB or the patient is known to be on therapy should be considered suspicious for a potential false-positive smear result (17). Some patients can shed dead AFB long after cultures are negative (18). AFB microscopy is not specific and will detect nontuberculous mycobacteria (NTM) and acid-fast environmental contaminants. It is essential not to introduce environmental contaminants when preparing reagents and during wash steps of the procedure. Patient AFB smears should only be examined and reported when control slides are acceptable. To avoid false-positive AFB smear readings (19):
- Use new, clean, greaseless, and unscratched slides.
- Match patient identifier on the slide with clinical specimens.
- Label slide with material that stays permanently affixed during the staining procedure (e.g., graphite or diamond tip pencil).
- Use a negative control slide to monitor environmental contaminants during the staining process.
- Use a positive quality control slide to ensure that staining occurs as expected.
- Avoid using bulk containers of reagents and carboys of water.
- Use filtered, distilled, or deionized water.
- Ensure slides do not touch on the staining rack. Do not use staining jars.
- Filter stains if precipitates are present.
- Wipe oil from lens after each AFB-positive smear is read if an oil immersion lens is used.
- Ensure that microscopists are competent before reading and reporting AFB smear results.
iii. Molecular Testing
For molecular testing that uses targeted amplification, it is important to prevent contamination of patient specimens with amplified nucleic acid (DNA) from other patient specimens (20). Assays that do not use targeted amplification still have the potential for cross-contamination between patient specimens. Laboratorians can reduce the risk of molecular contamination through:
- Use of separate workspaces for molecular testing allowing for separation of the different testing procedures and minimizing the risk of backflow contamination of amplicons.
Ideally, these workspaces would be separate rooms, but at the very least should be defined areas. The distinct molecular areas should be: the “reagent preparation room/area,” the “sample preparation room/area,” and the “amplification detection room/area (20).”
-
- The “reagent preparation room/area” and “sample preparation room/area” should both be considered clean areas.
- The “reagent preparation room/area” should be reserved for only reagent preparation and The room must not house any DNA, RNA, or patient specimens.
- The “sample preparation room/area” is where specimen preparation, nucleic acid extraction, and reaction set-up occur. This room should be under negative pressure to prevent the spread of aerosolized specimens, controls, or calibrators.
- The two pre-amplification rooms/areas (“reagent preparation room/area” and “sample preparation room/area”) should be cleaned before and after use with a 10-20% bleach solution followed by ethanol or clean distilled water or as recommended by equipment manufacturers for specific equipment or work spaces (16, 21).
- The “amplification detection room/area” is the post-amplification room where nucleic acid amplification and analysis occur. This room is considered “dirty” due to the manipulation of amplicons and should also be under negative pressure to minimize the risk of contamination.
- Routine laboratory cleaning of all rooms can reduce the risk of contamination from patient specimen DNA/RNA, controls, or amplicons.
- One of the most important practices to reduce contamination during molecular testing is to implement unidirectional workflow.
This practice ensures that work moves from clean (pre-amplification) to dirty (post- amplification) areas and decreases the potential for carryover or backflow contamination of amplicons. Laboratorians should limit their movements to unidirectional workflow: moving through the clean rooms (“reagent preparation room/area” and “sample preparation room/ area”) to the dirty room (“amplification detection room/area”) without going directly back to a previous room. Movement backwards between the rooms could result in introduction of DNA/ RNA or amplicons into a clean room, thus causing contamination and potentially false-positive results. - It is best practice to have dedicated equipment and personal protective equipment (PPE) for molecular testing within each of the defined rooms listed above (21).
Dedicated equipment and PPE will reduce contamination from exposure to patient specimens or amplicons. Specifically, pipettes, racks, ice buckets, and cooling blocks should be dedicated to specific tasks within each room and should use filtered tips to prevent aerosolization and contamination of pipettor barrels. PPE should be disposable when possible and gloves should be changed frequently. Many laboratories utilize a color-coding system to ensure that equipment and PPE are maintained in the appropriate rooms. Additionally, laboratorians should utilize best practices to prevent aerosolization and to minimize cross-contamination.If patient specimens, quality controls, or calibrators from the “sample preparation room/ area” are introduced to the “reagent preparation room/area” or if amplicons from the “amplification detection room/area” are introduced to either clean room, testing results can be compromised leading to contamination and questionable results. Thus, it is important to monitor clean rooms for potential contamination through the use of wipe tests (performed at least monthly and when troubleshooting) collected from various laboratory surfaces in the clean rooms. If a polymerase chain reaction (PCR) target is found, the area is considered contaminated and must be decontaminated immediately. An investigation must be performed to try to determine the source or practice that led to the contamination in order to prevent it from recurring in the future. - Laboratorians should use quality control measures to ensure testing runs are as expected. Specifically, no-template controls (also known as blank controls) are necessary.
No-template controls should consist of water, buffer, or specimen transport medium that is assayed with the testing reagents, but without patient specimens or nucleic acid. These negative controls are used to detect contamination of reagents or background signal. Controls ensure that the assay performed as expected and that patient results are accurate, reliable, and reportable.
C. Post-Analytic Prevention Practices

The accurate verification and reporting of laboratory results are essential. Post-analytic practices include all steps taken to verify and review results, to communicate results, and to provide easily interpretable results to submitting laboratories or healthcare providers. Laboratorians can reduce common post-analytic errors by:
- Reviewing test results to ensure the correct result was reported for the correct patient.
- Ensuring that data entry or transcription errors did not occur when results were entered into the laboratory information management system (LIMS).
- Verifying that the correct report was sent to the submitting laboratory and healthcare provider.
- Monitoring periodically whether reports of laboratory results and associated reporting language were received and interpreted correctly by the submitting laboratory or healthcare provider. This in turn also allows for laboratory review of report design, format and ease of use.
- Reviewing quality control results.
- Ensuring quality control procedures were followed (e.g., secondary review).
- Cross-referencing genotypes for samples in question to any known positives processed the same day or to the H37Rv/Ra control strain.
Laboratories should remain observant for potential false-positive results. This can be accomplished through routine monitoring of test results and by developing tools and practices that can assist in identifying false-positive results. Early detection includes benefits for patient management and public health.
A. Situations or Scenarios that Might Initiate an Investigation
A number of events should initiate an investigation into whether a result is a false-positive. Any one of the scenarios below should also be a reasonable trigger for a false-positive investigation. Keep in mind that this is not a comprehensive list, and there may be other situations when it might be beneficial to conduct a false-positive investigation.
- Single positive culture (liquid or solid) of multiple specimens from a new patient
Patients positive for MTBC should have consistent results in the diagnostic series. Results that are discordant within the set of diagnostic cultures could be indicative of a false-positive result (22, 23). Having only one positive liquid or solid media MTBC result out of multiple liquid or solid cultures for the same patient could be an indication of a false-positive result. Also, single positive specimens have been a sensitive predictor of cross-contamination in past investigations (8, 12, 24).
- Extended incubation time with late appearing growth (liquid media) or scanty growth (solid media)
Studies have demonstrated that most diagnostic cultures positive for MTBC will be detected within an average incubation time of 28 days (25, 26). A culture that has delayed growth on either liquid or solid media and low colony counts on solid media may be a cause for concern (27, 28). Time to positivity can be delayed if bacterial load in the specimen is low. A cluster of positive cultures that appear late with scanty growth (<10 colonies on solid media) or a delay in recovering mycobacteria in a liquid system may indicate that contamination occurred during processing (27).
- Negative control is AFB smear or culture positive
Having a negative AFB smear control slide test positive indicates contamination of the control, reagents, or the slide. Further investigation is needed before reading patient AFB smears. Similarly, AFB growth on culture media for the negative control indicates that contamination occurred in the processing batch or that the media itself was contaminated. All culture results from that processing batch should be reviewed since the results are invalidated by the positive result in the negative control. If results have been reported, corrected reports should be issued and providers should be notified.
- Increase of isolates with species that are rare for the laboratory or with environmental contaminants
Routine laboratory monitoring of the incidence of each species identified (MTBC and NTM) could detect an increase in a rare species not commonly seen in the laboratory, which could be suggestive of an increase in laboratory contamination. Similarly, a sudden increase in the percentage of a species typically found to be environmental contaminants (e.g., M. gordonae) could be a sign of contaminated water or reagents (29).
- Unusual increase in isolates with identical drug resistance patterns
If a laboratory experiences an unusual increase in MTBC isolates with identical drug resistance patterns, this may suggest possible false-positive results. The laboratory should determine whether cross-contamination may have occurred during specimen processing or culture manipulation set up for isolate identification or drug susceptibility testing (30, 31). Laboratories should collaborate with the program’s surveillance or epidemiology team to assess whether there is a suspected cluster with epidemiologic links, or if the same patient was tested but with different identifying information (e.g., mislabeled). Genotyping results should also be reviewed for each of the isolates.
- Unusual genotyping results, possibly involving proficiency testing or quality control strains

Unusual genotyping results, such as results from patient specimens that are identical to laboratory PT or QC strains, indicate false-positive results. Particular strains of MTBC have been chosen for PT and QC strains for differentiation from strains that circulate in the general population. When these strains are found during genotyping, it is more likely that these results are an indication of a false-positive MTBC result. The exception is whether the isolate could be from a possible laboratory exposure.
- Increase in percentage of culture positivity
An increase in the percentage of positive MTBC culture results in a laboratory could be a sign of false-positive results, especially if there is no other feasible explanation (e.g., an outbreak). Any increase in culture positivity should be investigated. Routine monitoring of laboratory indicators, such as total number and percent of positive cultures belonging to MTBC, will allow for proactive assessment. Additionally, monitoring these data and maintaining communication with the TB Program could assist in explaining test results. Genotyping results should also be reviewed when an increase in positive culture results are investigated.
- Nucleic acid amplification test (NAAT) positive specimens that are AFB smear and culture negative
A single positive NAAT result would be considered suspicious if AFB smear and culture were negative (37). Results need to be correlated with other diagnostic findings and patient history. Single positive NAAT results could be due to contamination or the detection of non-viable organisms in patients on treatment.
B. Monitoring Tools
Below are examples of monitoring strategies/activities that can aid the laboratory in identifying or preventing false-positive test results. Best practice monitoring activities may include:
- Review of patient’s past results and current test orders at time of testing
Reviewing a patient’s previous test results when setting up current testing will help identify whether the patient has been previously positive for MTBC. By identifying this early on, the current specimen can be placed appropriately within the processing batch to minimize potential cross-contamination.
- Review of patient’s past results at time of reporting
Reviewing a patient’s previous test results when reporting out a positive result report will help to determine whether the patient is a new positive or is consistent with previous results for that patient.
- For newly diagnosed patients, check if there were other positive specimens in the same batch
When a specimen is identified as positive for MTBC, it is good practice to determine if other positive patient specimens were in the same batch (e.g., processing, identification or drug susceptibility testing). This helps to rule out or to identify the possibility of cross-contamination from other known MTBC positive specimens processed in the same batch. Studies show that multiple positive patient cultures from the same processing batch may be associated with an increased likelihood of false-positive results (22). However, it is important to determine a laboratory’s normal positivity rate as a baseline for comparison.
- Periodic monitoring of all test results
Many laboratories perform monthly or quarterly review of all MTBC results to monitor for inconsistent or remarkable results. Unusual patient or laboratory findings could include but are not limited to: same collection facilities, clusters of positive growth for multiple patient specimens processed on the same day, no clinical symptoms associated with positive culture results, or genotypes matching laboratory controls.
- Documentation (e.g., logs and lot numbers) to determine possible false-positive causes
Maintaining accurate and complete records including specimen processing logs, lot numbers, or quantity of specimen received can assist in identifying potential causes of an unusual or nonconforming event that leads to a potential false-positive. Logs or notes could provide critical details, which are especially important when the investigation is conducted weeks later, after an MTBC identification or unusual drug-resistance pattern has been determined. Using this information could prevent erroneous reporting or assist a false-positive investigation.
- Monitoring of results triggered by external inquiries
While it is advisable to monitor laboratory procedures and policies proactively, laboratories may receive inquiries from a healthcare provider or TB Program regarding test results. It may be necessary to initiate an investigation based on these inquiries to provide as much information to the healthcare provider or TB Program for appropriate patient care. Development of a laboratory procedure to review specimen processing logs, patient history, susceptibility patterns, and genotyping for suspected false-positive cases should be implemented.
Retrospective identification of false-positive MTBC results is accomplished through active and passive surveillance by both TB Programs and healthcare providers. This monitoring is critical in addition to laboratory monitoring. Communication between TB Programs, healthcare providers, and laboratories must remain open and is essential when results are questionable.
A. TB Program

Through monitoring or review of case results, the TB Program should alert the testing laboratory and healthcare provider of any patient suspected of having a false-positive result and an investigation should be initiated. Based on evidence from the investigation, genotyping can be requested (if not already reported) from the National Tuberculosis Molecular Surveillance Center to aid in the determination of a false-positive result. If the investigation leads to the conclusion that a false-positive result is likely, the TB Program should:
- Communicate with the laboratory to make an assessment and determine the likelihood of false-positives,
- Alert the healthcare providers so that the patient can be correctly diagnosed and treated (therapy discontinued or modified),
- Alert the healthcare facility or laboratory involved so that the cause of the false-positive result can be investigated and corrected (32), and
- Alert surveillance staff to ensure accuracy of documented laboratory results and case counts.
Monitoring by TB Programs consists of two main areas:
i. Review of Patients with Positive Cultures (33)
Medical records should be reviewed and healthcare providers should be communicated with to identify patients who, despite a positive test for MTBC, do not fit the typical clinical presentation:
- Patients diagnosed with pulmonary TB who exhibit normal chest radiographs
- Patients diagnosed with a different condition before TB culture results are reported
- Patients with a negative interferon gamma release assay (IGRA) ortuberculin skin test (TST) result
- Patients not started on treatment for TB
- Patients started on TB treatment only after culture results were reported
- Patients with multiple specimens but only one culture positive for MTBC
- Patients with follow-up specimens collected to monitor treatment response (i.e., culture conversion) that only grew NTMs
ii. Molecular Epidemiology
Identical genotyping results for those specimens tested in the same batch derived from multiple patients should be verified with clinical presentation or epidemiology.
- Recognize patients with identical genotypes and confirm a relationship using epidemiologic links.
- Identify genotypes within a jurisdiction that are uncommon.
- Recognize laboratory PT or QC strain genotypes.
The TB Program might investigate:
i. Route of the patients’ specimens from collection to receipt in the laboratory to identify possible pre–analytic errors that could have resulted in contamination or mislabeling.
- Sputum collection
-
- Where (TB Clinic, hospital, clinical laboratory, home)
- When (collected at same time as other patient specimens
- How (routine collection, induced sputum, bronchoscope use)
- What (collection container issues)
- Who (patient by themselves, or overseen by a provider)
- Specimen labeling/requisition forms
ii. Genotyping results as part of TB control practices
- Review epidemiology of patients within a genotype cluster to aid in determination of a false-positive result (e.g., rare strains in multiple patients over a short time span, matching genotypes among seemingly unrelated patients, and unexpected strains based on patient demographics)
- Review discordant genotypes among specimens from the same patient
- Compare genotypes to QC strains or laboratory PT strains that have been submitted for genotyping
B. Healthcare Provider
A healthcare provider may suspect a false-positive laboratory result when a patient has a positive TB test result but no signs/symptoms of TB, clinical presentation that is inconsistent with TB, or radiographic findings that are inconsistent with TB. In addition, a healthcare provider may suspect cross-contamination if multiple specimens have been submitted for a patient and only one is culture-positive, while all have negative AFB smears (11, 15). Other patient indicators that may initiate a false-positive TB investigation include:
- Patient has no risk factors for TB,
- Negative IGRA or TST result,
- Chest radiograph not improved after two or more months of anti-tuberculosis medications,
- New positive culture in a patient who previously culture converted,
- New positive culture with a different susceptibility pattern,
- History of previous NTM infection, and/or
- Follow-up cultures for monitoring treatment response (i.e., culture conversion) only grow NTMs.
A false-positive investigation can be initiated by a laboratory, TB Program, healthcare provider, or submitter. Recall that false-positives may be caused by a variety of reasons, including laboratory cross-contamination, contamination of a clinical device or container during specimen collection, and clerical error prior to specimen receipt in the laboratory. If the laboratory determines that a false-positive result has potentially occurred, the laboratory should notify the TB Program and healthcare provider in a timely manner. When reviewing patient results and epidemiologic factors during routine surveillance activities, TB Programs may notice results that are not consistent with patient history. In this situation, the TB Program should notify the laboratory and healthcare provider immediately.
When test results are questioned as potential false-positives, justification should be provided when requesting or initiating an investigation. This justification should include the reason for the investigation, patient identifiers, laboratory/specimen accession numbers including date of receipt in the laboratory, patient clinical presentation and history, and patient test results from all laboratories where testing was performed.
After communication is established with all essential persons, an investigation strategy should be developed for every false-positive inquiry. Consideration should be given to laboratory procedures and policies, patient clinical presentation and history, and specimen collection practices. Collaboration among the laboratory, TB Program, healthcare providers, and submitters in a potential false-positive investigation is essential.

When a false-positive test result is suspected, it is important to review all information or data related to the laboratory testing of the specimen(s). Investigations should include:
- Review of specimen processing log for possible clerical error(s)
The laboratory specimen processing log is a record of information about when specimens are initially processed and tested. Review the specimen processing log for accuracy and notes of incidents that may have occurred during processing. Pay attention to possible clerical errors related to the order of the specimens processed or transcription errors. Also, determine if a large number of specimens were processed in one batch. If another department is responsible for accessioning patient specimens, it may be beneficial to inquire about the process used to organize, label, and enter information or data about patient specimens (34). - Review of laboratory specimen processing log to determine if known MTBC positive patients or highly AFB smear-positive specimens were processed in the same batch
Contamination from a positive to a negative specimen is more likely to occur in specimen processing runs in which MTBC positive specimens are processed alongside new patient specimens. Additionally, highly AFB smear-positive specimens can also be the contamination source for a false-positive result due to the high bacterial burden in the smear-positive specimen (35, 36). - Review of genotyping test results
Genotyping analyzes the genetic material (e.g., DNA) of MTBC. The genotype of a suspected false-positive isolate may match the genotype of the isolate that was the suspected source of the contamination (36). When possible, another specimen from the patient(s) should be sent for genotyping.
- Results match MTBC isolate from another patient specimen processed in the same batch
Matching genotype results of a new MTBC positive patient with a previous MTBC positive patient or multiple MTBC positive patients with matching genotypes may suggest that there was cross-contamination during specimen processing (35, 36). - Results differ for specimens from the same patient collected on different dates
When multiple patient specimens in a diagnostic series are submitted over time with varying test results, this may suggest that a possible error in testing has occurred. If the patient isolates have different genotypes, then this is likely the result of contamination. However, this is not always the case. - Results match a laboratory PT or QC strain
If an isolate from a patient specimen has a genotype that matches a laboratory PT or QC strain, this may identify the source of contamination that caused the false-positive result. PT samples and positive QC strains to be used as controls should not be processed with patient specimens. Procedures should be reviewed if the same BSC or pipette was used to process PT specimens during a previous batch or if the same bottles of reagents were used for both PT or QC and patient specimen processing. - Speak with the TB Program or healthcare provider to determine if patient symptoms are consistent with TB disease
Laboratory and clinical results should be consistent. Clinical symptoms of TB disease are a good indicator of a true positive specimen result, while the absence of clinical symptoms would suggest a false-positive result in most cases (35, 37). On occasion, false-positive results can occur in a patient with TB disease. - Inquire with submitter to determine if patients with previous MTBC positive specimens were collected on the same day in the same location
It is important to ensure that a patient collection container is associated with the correct patient specimen. Patient specimens collected on the same day or in the same location increases the potential for specimen mix-up. This is especially concerning if patient specimens previously identified as MTBC are collected with other patient specimens on the same day or at the same time at the same location. Contamination has been noted from the same location using the same collection instruments such as bronchoscopes (38, 39). - Inquire with submitter to determine if label on specimen collection container and patient information match
It is important to properly label patient collection containers. Clerical errors can occur when specimens are being prepared for submission to the laboratory. Patient information and specimen collection containers should be checked for accuracy and to ensure the patient information matches. - Review of growth rate of cultures and colony counts to determine likelihood of carry-over or media inoculation error
Laboratory-specific data should include a record of culture growth rates for MTBC-positive specimens. False-positive specimens, resulting from carry-over during specimen processing, will most likely have fewer organisms compared to a known MTBC-positive specimen. Slower growth rate and lower colony counts have been observed with false-positive specimens (35, 36). - Ensure staff are following standard operating procedure(s) and observe technique(s) for best practices
All laboratory standard operating procedures should be followed. Excessive work schedules, reduced staffing, and large specimen processing batches, can all contribute to errors and potential contamination of specimens. Regular observation of technique and review of best practices should be implemented for all staff (40). It may be beneficial during an investigation to speak with staff who performed the testing to understand if anything unusual with the specimen processing batch occurred. - Review of nonconforming event (NCEs) logs for events that may have occurred
Nonconforming event reporting keeps track of irregular events that occur in the laboratory (e.g., departure from a documented requirement or procedure such as a regulation, statute, policy, procedure, customer requirement). These events could contribute to either a false-positive result or ongoing laboratory issues that need to be resolved. - Review lot numbers of reagents/media/kits

Reagents, media, and kits used for processing patient specimens need to be acceptable for use and not expired. Expired reagents, media, or kits can affect data quality and may lead to improper results.
- In-house review of documented reagent/media/kit lot issues
Recurring errors with testing could suggest a problem with a reagent, media, or kit component. Ensure that reagents, media, and kits are stored at the proper temperature and that any in-house preparation is performed per manufacturer’s instruction. When reagent, media, or kit materials expire, they may no longer work effectively, which can lead to inaccuracies that affect data quality.
- In-house review of documented reagent/media/kit lot issues
-
- Contact reagent/media/kit manufacturers to determine if there are reported lot issues
There may be unknown manufacturing errors in certain reagent, media, or kit components. Manufacturers should be contacted to determine if there have been issues with particular lots of reagents, media, or kits and other user complaints.
- Contact reagent/media/kit manufacturers to determine if there are reported lot issues
Throughout a false-positive investigation, communication among all partners is vital. The laboratory should provide updates to the TB Program and healthcare providers as new information becomes available. Similarly, the TB Program and healthcare provider should keep the laboratory aware of any pertinent information regarding patients including clinical presentation and epidemiologic investigations. Forming a committee consisting of both laboratory and the TB Program representatives is beneficial for awareness and future collaboration. If the patient is hospitalized, it is also important that the facility’s infection prevention team is aware of the concern of a false-positive result.
A suspected false-positive result should be considered “likely” if one or more of the following criteria are met:
- Genotyping shows a match with the presumed source of the false-positive result
- The investigation confirmed that the questionable isolates have a common linkage (e.g., exposed during manipulation)
- There is no other likely explanation for the findings
- The presumed misdiagnosed patient does not have a clinical presentation consistent with TB
Depending on the outcome of the false-positive investigation, it may be appropriate to update or correct patient test results. While not a substitute for clinical judgement, a thorough false-positive investigation is important to ensure healthcare providers receive accurate patient test results to consider when making patient treatment decisions. The ability to provide corrected reports may depend on the functionality of the laboratory information management system. The laboratory should communicate with the TB Program and healthcare providers regarding progress of the investigation including specific patient test results.
Within the laboratory and outside of the laboratory, the conclusion of a false-positive investigation provides the opportunity for reeducation, additional training, or reassessment of policies and procedures. Additionally, this is an opportunity to ensure that laboratorians are performing best practices through competency training.
Laboratories should consider the importance of developing a policy related to false-positive investigations. This policy should include common steps, flags, or scenarios that the laboratory can monitor to proactively assess whether a false-positive investigation is necessary, as well as a communication plan for involved partners. A false-positive investigation policy is necessary for consistent and accurate communication among the laboratory, TB Program, hospitals, and healthcare providers and for appropriate patient care.
1. CLSI, Laboratory Detection and Identification of Mycobacteria, 2nd ed., in CLSI guideline M48. 2018. Clinical and Laboratory Standards Institute: Wayne, PA.
2. APHL. Training Module: Specimen Collection, Transport, Handling, and Processing. Essentials for the Mycobacteriology Laboratory: Promoting Quality Practices; Available from https://www.aphl.org/programs/infectious_disease/tuberculosis/Pages/Training-Modules.aspx
3. APHL. Guidelines for Submission of Sputum Specimens for Tuberculosis Testing. https://www.aphl.org/aboutAPHL/publications/Documents/ID-2018Apr-Guidelines-TB-Sputum-Submission.pdf
4. WHO. Mycobacteriology Laboratory Manual. First Edition. April 2014. Global Laboratory Initiative. https://stoptb.org/wg/gli/assets/documents/gli_mycobacteriology_lab_manual_web.pdf
5. Ramos MC, Soini H, Roscanni GC, Jaques M, Villares MC, Musser JM. Extensive cross-contamination of specimens with Mycobacterium tuberculosis in a reference laboratory. J Clin Microbiol, 1999 Apr;37(4):916-9.
6. Carrol, NM, Richardson M, Engelke E, de Kock M, Lombard C, van Helden PD. Reduction of the rate of false-positive cultures of Mycobacterium tuberculosis in a laboratory with a high culture positivity rate. Clin Chem Lab Med 2002 40(9):888-92.
7. Carrol, NM, Richardson M, van Helden PD. Criteria for Identification of cross-contamination of cultures of Mycobacterium tuberculosis in routine microbiology laboratories. J Clin Microbiol 2003 May;41(5):2269-70.
8. Jasmer RM, Roemer, M, Hamilton J, Bunter, J, Braden CR, Shinnick TM, Desmond EP. A prospective, multicenter study of laboratory cross-contamination of Mycobacterium tuberculosis cultures. Emerg Infect Dis 2002 Nov; 8(11):1260-3.
9. Maurer JR, Desmond EP, Lesser MD, Jones WD Jr. False-positive cultures for Mycobacterium tuberculosis. Chest 1984 Sept; 86(3):439-43.
10. Van Duin JM, Pijnenburg JEM, Van Rijswoud CM, de Haas PEW, Hendricks WDH, van Sooligan D. Investigation of cross contamination in a Mycobacterium tuberculosis laboratory using IS6110 DNA fingerprinting. Int J Tuberc Lung Dis 1998 May;2(5):425-9.
11. Poynten, M, Andresen DN, Gottlieb. Laboratory cross-contamination of Mycobacterium tuberculosis: an investigation and analysis of causes and consequences. Internal Med J 2002 Nov;32(11):512-9.
12. Burman WJ, Stone BL, Reves RR, Wilson ML, Yang Z, El-Hajj H, Bates JH, Cave MD. The incidence of false-positive cultures of Mycobacterium tuberculosis. Am J Respir Crit Care Med 1997 Jan;155(1):321-6.
13. Breese PE, Burman WJ, Hildred M, Stone B, Wilson ML, Yang Z, Cave, MD. The effect of changes in laboratory practices on the rate of false-positive cultures for Mycobacterium tuberculosis. Arch Pathol Lab Med 2001 Sept;125(9):1213-16.
14. Fitzpatrick L, Braden C, Cronin W, English J, Campbell S, Valway S, Onorato I. Investigation of laboratory cross-contamination of Mycobacterium tuberculosis cultures. Clin Infect Dis 2004 March;38(6): e52-4.
15. MMWR. Misdiagnoses of Tuberculosis Resulting From Laboratory Cross-Contamination of Mycobacterium Tuberculosis Cultures — New Jersey, 1998 2000 May 19;49(19):413-6.
16. Esco Technologies, Inc. A Guide to Biosafety & Biological Safety Cabinets. 2013 http://escolifesciences.us/resources/guide-to-biosafety-and-biological-safety-cabinets/13/
17. Lee JS, Kim EC, Joo SI, Lee SM, Yoo CG, Young WK, Han SK, Shim YS, Yim JJ. The incidence and clinical implication of sputum with positive acid-fast bacilli but negative in mycobacterial culture in a tertiary referral hospital in South Korea. J Korean Med Sci 2008 Oct;23(5):767–71.
18. Kang HK, Jeong BH, Lee H, et al. Clinical significance of smear positivity for acid-fast bacilli after ≥5 months of treatment in patients with drug-susceptible pulmonary tuberculosis. Medicine 2016 Aug;95(31): e4540.
19. APHL. Training Module: AFB Smear Microscopy. Essentials for the Mycobacteriology Laboratory: Promoting Quality Practices; Available from: https://www.aphl.org/programs/infectious_disease/tuberculosis/Pages/Training-Modules.aspx
20. CLSI, Establishing Molecular Testing in Clinical Laboratory Environments; Approved Guideline, in CLSI guideline MM19-A. 2011. Clinical and Laboratory Standards institute: Wayne, PA.
21. CLSI, Molecular Diagnostic Methods for Infectious Diseases, in 3rd ed. CLSI guideline MM03. 2015. Clinical and Laboratory Standards Institute: Wayne, PA.
22. Lai CC, Tan CK, Lin SH, Liao CH, Chou CH, Huang YT, Hsueh PR. Molecular evidence of false-positive cultures for Mycobacterium tuberculosis in a Taiwanese hospital with a high incidence of TB. Chest. 2010 May;137(5):1065-70.
23. Burman WJ, Reves RR. Review of false-positive cultures for Mycobacterium tuberculosis and recommendations for avoiding unnecessary treatment. Clin Infect Dis. 2000 Dec;31(6):1390-5.
24. Frieden TR, Woodley CL, Crawford JT, Lew D, Dooley SM. The molecular epidemiology of tuberculosis in New York City: the importance of nosocomial transmission and laboratory error. Tuber Lung Dis. 1996 Oct;77(5):407-13.
25. Tyrrell FC, Budnick GE, Elliott T, Gillim-Ross L, Hildred MV, Mahlmeister P, Parrish N, Pentella M, Vanneste J, Wang YF, Starks AM. Probability of negative Mycobacterium tuberculosis complex cultures based on time to detection of positive cultures: a multicenter evaluation of commercial-broth-based culture systems. J Clin Microbiol. 2012 Oct;50(10):3275-82.
26. Kent PT, Kubica, GP. Public health mycobacteriology: a guide for the level III laboratory. Atlanta, GA: U.S. Dept. of Health and Human Services, Public Health Service, Centers for Disease Control, 1985.
27. Bauer J, Thomsen VO, Poulsen S, Andersen AB. False-positive results from cultures of Mycobacterium tuberculosis due to laboratory cross-contamination confirmed by restriction fragment length polymorphism. J Clin Microbiol. 1997 Apr;35(4):988-91.
28. Braden CR, Templeton GL, Stead WW, Bates JH, Cave MD, Valway SE. Retrospective detection of laboratory cross-contamination of Mycobacterium tuberculosis cultures with use of DNA fingerprint analysis. Clin Infect Dis. 1997 Jan;24(1):35-40.
29. Stine TM, Harris AA, Levin S, Rivera N, Kaplan RL. A pseudoepidemic due to atypical mycobacteria in a hospital water supply. JAMA. 1987. Aug;14(258):809-11.
30. Bearman G, Vaamonde C, Larone D, Drusin L, Zuccotti G. Pseudo-outbreak of multidrug-resistant Mycobacterium tuberculosis associated with presumed laboratory processing contamination. Infect Control Hosp Epidemiol. 2002. Oct;23(10):620-2.
31. Centers for Disease Control and Prevention and Association of State and Territorial Public Health Laboratory Directors. Recognition and prevention of false-positive test results in mycobacteriology. 1997. http://www.cy118119.com/mmwr/preview/mmwrhtml/00049724.htm
32. Centers for Disease Control and Prevention (CDC). Guide to the application of genotyping to tuberculosis prevention and control. 2012. http://www.cy118119.com/tb/programs/genotyping/chap6/6_apply_3_suspected.htm
33. Tuberculosis Clinical Policies and Protocols Manual. 4th ed. Bureau of Tuberculosis Control. New York City Department of Health and Mental Hygiene. 2008. https://www1.nyc.gov/site/doh/providers/health-topics/tb-hosp-manual.page
34. Aber VR, Allen BW, Mitchison DA, Ayuma P, Edwards EA, Keyes AB. Quality control in tuberculosis bacteriology: Laboratory studies on isolated positive cultures and the efficiency of direct smear examination. Tubercle. 1980 Sep;61(3):123-33.
35. Bhattacharya M, Dietrich S, Mosher L, Siddiqui F, Reisberg BE, Paul WS, Warren JR. Cross-contamination of specimens with Mycobacterium tuberculosis: clinical significance, causes, and prevention. Am J Clin Pathol. 1998 Mar;109(3):324-30.
36. Small PM, McClenny NB, Singh SP, Schoolnik GK, Tompkins LS, Mickelsen PA. Molecular strain typing of Mycobacterium tuberculosis to confirm cross-contamination in the mycobacteriology laboratory and modification of procedures to minimize occurrence of false-positive cultures. J Clin Microbiol. 1993 Jul;31(7):1677-82.
37. Theron G, Venter R, Calligaro G, Smith L, Limberis J, Meldau R, Chanda D, Esmail A, Peter J, Dheda K. Xpert MTB/RIF Results in Patients With Previous Tuberculosis: Can We Distinguish True From False Positive Results? Clin Infect Dis. 2016 Apr 15;62(8):995-1001.
38. Wenzel RP, Edmond MB. Tuberculosis infection after bronchoscopy. JAMA. 1997 Oct;278(13):1111.
39. Michele TM, Cronin WA, Graham NMH, et. al. Transmission of Mycobacterium tuberculosis by a fiberoptic bronchoscope: identification by DNA fingerprinting. JAMA. 1997 Oct;278(13):1093-95.
40. CLSI, Training and Competence Assessment; Approved Guideline, in CLSI guideline QMS03-Ed4. 2016. Clinical and Laboratory Standards institute: Wayne, PA.
Acknowledgments
Special thanks to U.S. state and local public health laboratories and TB Programs and the Association of Public Health Laboratories for content and critical review.
